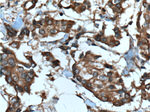
STK38 Antibody in Immunohistochemistry (Paraffin) (IHC (P))
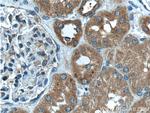
STK38 Antibody in Immunohistochemistry (Paraffin) (IHC (P))

Search
Proteintech
STK38 Polyclonal Antibody
{{$productOrderCtrl.translations['antibody.pdp.commerceCard.promotion.promotions']}}
{{$productOrderCtrl.translations['antibody.pdp.commerceCard.promotion.viewpromo']}}
{{$productOrderCtrl.translations['antibody.pdp.commerceCard.promotion.promocode']}}: {{promo.promoCode}} {{promo.promoTitle}} {{promo.promoDescription}}. {{$productOrderCtrl.translations['antibody.pdp.commerceCard.promotion.learnmore']}}
产品信息
55335-1-AP
种属反应
宿主/亚型
分类
类型
抗原
偶联物
形式
浓度
规格
纯化类型
保存液
内含物
保存条件
运输条件
产品详细信息
This antibody recognizes the C-terminal of STK38.
靶标信息
STK38 (also known as NDR) or Nuclear Dbf2-related protein is a serine/threonine kinase in the subgroup of the AGC kinase family that is regulated by Mob proteins. Fas and TNFα receptor stimulation activates human STK38 by promoting phosphorylation at the hydrophobic motif. NDR acts as a novel pro-apoptotic kinase, and is a key member of the RASSF1A/MST1 signaling cascade. STK38 is crucial for the fidelity of mitotic chromosome alignment in mammalian cells. STK38 is incorporated into the HIV-1 particles and is cleaved by the HIV-1 protease. STK38-driven centrosome duplication requires Cdk2 activity, and Cdk2-induced centrosome amplification is affected upon reduction of STK38 activity.
仅用于科研。不用于诊断过程。未经明确授权不得转售。
生物信息学
蛋白别名: Ndr Ser/Thr kinase-like protein; NDR1 protein kinase; Nuclear Dbf2-related kinase 1; Serine/threonine-protein kinase 38; stk38; unnamed protein product
基因别名: 5830476G13Rik; 9530097A09Rik; AA617404; NDR; NDR1; STK38
UniProt ID: (Human) Q15208, (Mouse) Q91VJ4
Entrez Gene ID: (Human) 11329, (Mouse) 106504